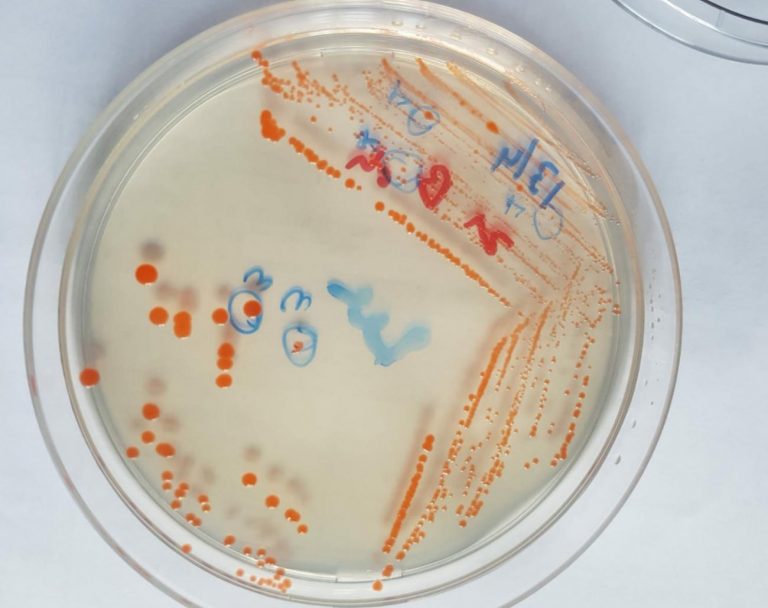
Hallazgo de bacteria en la Antártida

Proyecto uruguayo en la Antártida logró aislar bacteria que denominó «Hymenobacter artigasi» El científico uruguayo Dr. Javier...
Día: 17 de julio de 2020
Los tiempos de la Justicia ponen aprueba un poco más la voluntad y perseverancia de un trabajador...
En la Comisión de Hacienda de la Cámara de Senadores se está analizando el proyecto de ley...
MIENTRAS SIGUEN BAJANDO LOS CASOS DE COVID 19 EN NUESTRA CIUDAD SE SUMAN MAS EN MEDICA URUGUAYA,...
Tras acuerdo arribado, el mismo deberá de presentarse en la Seccional de su domicilio una vez a...
JUZGADO DE PAZ DEPARTAMENTAL DE TREINTA Y TRES EDICTO: Por disposición de la Señora Juez de Paz...